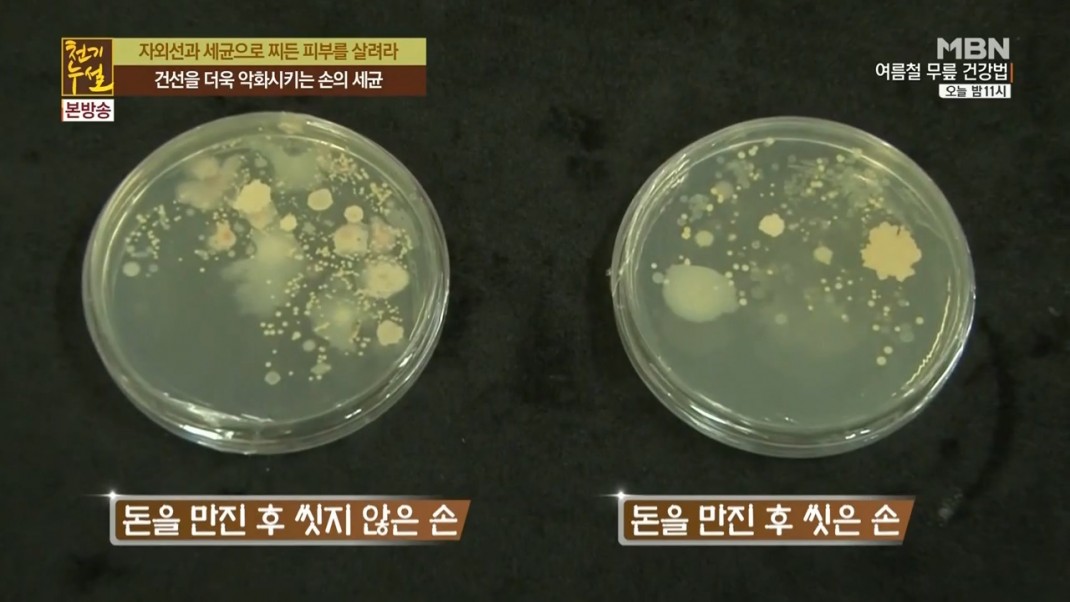
c5a37fdabcfe8af3e23b7b3f061f9896_1466063630_93.jpg

분석/연구용역 간편상담
담당 연구원 확인 후
연락드리겠습니다.
24시간동안 이 창을 열지않음
분석/연구용역 간편상담
담당 연구원 확인 후
연락드리겠습니다.
24시간동안 이 창을 열지않음
공지사항
생명공학 분야의 선두주자로서 신뢰성 있는 연구성과를 제공합니다.MBN 천기누설 : 한국의과학연구원_방송부문연구지원
작성자관리자
본문
MBN 천기누설 - 2016년 6월12일
* 자외선과 세균으로 찌든 피부를 살려라! :
목적 : 1. 지폐에 닿은 손에 존재하는 세균 분석지원
2. 어성초의 항균력 분석지원
결과 : 1. 지폐에 닿은 손에서는 9배 이상의 세균 검출 확인.
2. 무좀을 일으키는 칸디다균을 대상으로 어성초 항균력 확인.